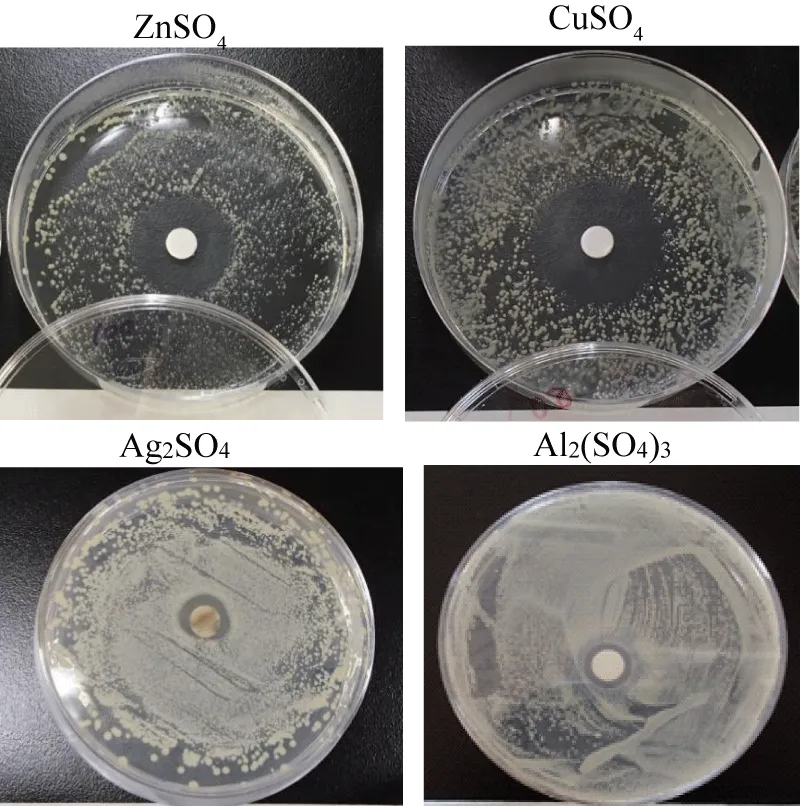

More Information
Submitted: March 12, 2026 | Approved: March 23, 2026 | Published: March 24, 2026
Citation: Ishida T, Kobayashi R. Bacteriolysis Destruction for Cu- and Zn-Ions Induced Peptidoglycan Cell Wall Based on the Halo-test Results in Cu(NO3)2 and ZnSO4 Solutions against Staphylococcus epidermidis. Int J Clin Microbiol Biochem Technol. 2026; 9(1): 010-017. Available from:
https://dx.doi.org/10.29328/journal.ijcmbt.1001034
DOI: 10.29328/journal.ijcmbt.1001034
Copyright license: © 2026 Ishida T, et al. This is an open access article distributed under the Creative Commons Attribution License, which permits unrestricted use, distribution, and reproduction in any medium, provided the original work is properly cited.
Keywords: Zinc(Ⅱ) and copper(Ⅱ); Halo-test; Copper nitrate and zinc sulfate; PGN biosynthesis; Autolysin and elongation; S. aureus PGN cleavage; Hydrolysis and decomposition
Abbreviations: Eps: Endopeptidase; PGN: Peptidoglycan; PGRPs: Peptidoglycan Recognition Protein; PTEN: 403 Amino Acids; LYS1: Lysozyme1; MIC: Minimum Inhibitory Concentration; MBC: Minimum Bactericidal Concentration; PRRs: Pattern Recognition Receptor; TG: Transglycosylase; TP: Transpeptidase
Bacteriolysis Destruction for Cu- and Zn-Ions Induced Peptidoglycan Cell Wall Based on the Halo-test Results in Cu(NO3)2 and ZnSO4 Solutions against Staphylococcus epidermidis
Tsuneo Ishida1* and Reiko Kobayashi2
1Professor (Former), Aerospace Engineering Department, Teikyo University, Retired, Independent Researcher, 2-3-6 Saido, Midori-ku, Saitama-shi, Saitama 336-0907, Japan
2Chemistry Teacher, Kumagaya Women’s High School, Anti-Bacterial Metal-Sulfates and Nitrates Halo-Test Research Group, 2-131 Suehiro-cho, Kumagaya-shi, Saitama 360-0031, Japan
*Corresponding author: Dr. Sci. Tsuneo Ishida, Professor (Former), Aerospace Engineering Department, Teikyo University, Retired, Independent Researcher, 2-3-6 Saido, Midori-ku, Saitama-shi, Saitama 336-0907, Japan, Email: [email protected]
Bacteriolysis of peptidoglycan (PGN) cell wall destruction on cleavage, hydrolysis, and decomposition by copper nitrate and zinc sulfide solutions has been investigated on the ground of the results obtained from halo antibacterial susceptibility tests in metal sulfate solutions against Staphylococcus epidermidis, in which from halo-antibacterial susceptibility tests of metallic ion concentration of 100 mM/L against Staphylococcus epidermidis, the order of bacterial effect for the metal nitrate solutions is as follows, Cu2+>Zn2+ >Ag+>Pb2+>Al3+, and the other, in the metal sulfate solutions, the antibacterial effect order is found to be Zn2+>Cu2+>Ag+>Al3+.
Cu(Ⅱ)-, Zn(Ⅱ)-ions induced bacteriolytic destructions for PGN cell wall on cleavage, hydrolysis, and decomposition within Cu(NO3)2 and ZnSO4 solutions have been elucidated that ①Cu(Ⅱ) and Zn(Ⅱ) ions can inhibit PGN biosynthesis Transpeptidase (TP)/Trans-glycosylase (TG) and PGN elongation, ②PGN cleavage occurs by copper ions- and zinc ions-containing autolysins amidase; AmiE, Rv3717, AmiA, ③PGN cell wall is hydrolyzed by copper-, and zinc-containing enzymes; PGRPs, MurA, LytA, LytM=Endopeptidase, Hydrolase LytB, and ④PGN decomposition by copper-, zinc-containing PGN inhibitive elongation occurs. Thus, Cu(Ⅱ) and Zn(Ⅱ) within Cu(NO3)2 and ZnSO4 solutions inhibit PGN biosynthesis and activate bacterial PGN autolysins against Staphylococcus epidermidis.
In Cu(NO3)2 solution, antibacterial Cu(NO3)2 solution is used the antimicrobial activity of a novel, plasma-cured 2.5% (w/v) Cu(NO3)2-containing sol–gel surface was performed as sol–gel coatings, the plasma curing led to a gradient in cross-linking with the highest values at the top of the coating [1], the other, in ZnSO4 solution, ZnSO4 different concentrations of zinc sulfate were found to have antibacterial effect against multidrug resistant Staphylococcus aureus, Staphylococcus epidermidis, Escherichia coli, Proteus spp.[2]. Bacterial clearance was improved in mice pretreated with PGN, as the effect of PGN pretreatment was not due to any LPS contamination, by showing that exposure to the Gram-positive bacterial cell wall component peptidoglycan also induces cross tolerance to LPS and non-specifically enhances innate immune function, in that PGN-pretreated mice had increased resistance to Gram-negative bacterial challenge [3].
Bacteriolytic mechanism for Ag+, Cu2+, Zn2+ ions, respectively, induced S. aureus is clarified that bacteriolysis and destruction of S. aureus PGN cell wall occur by inhibition of PGN elongation through metallic Ag+, Cu2+, Zn2+ ions-induced PGN inhibitory transglycosylase (TG) and transpeptidase (TP) syntheses (TG for Zn2+) and PGN activated major autolysin of amidase. The other, bacteriolytic mechanism for Ag+, Cu2+, Zn2+ ions, respectively, induced E. coli is found that bacteriolysis and destruction of E. coli cell wall occur by disruption of E. coli outer membrane (OM) structure with OM lipoprotein-endopeptidase activation, and by inhibition of PGN elongation through inhibitory TG and TP syntheses (TG for Zn2+) and PGN-activated major autolysins [4].
The other, bacterial PGN cleavage and hydrolysis, plays important roles in anti-bacterial functions. Zinc-induced bacterial PGN cleavage is composed of decomposition and hydrolysis, in which bacterial killing occurs by PGN cell wall destruction through a balanced reaction between PGN suppressive biosynthesis and activated autolysin. PGN cleavage is involved, in which AmiA distinguishes PGN mostly by the peptide, and cleavage is facilitated by a zinc-activated water molecule [5]. Peptidoglycan (PGN) recognition proteins (PGRPs) are pattern recognition receptors of the innate immune system that bind and, in some cases, hydrolyze bacterial PGN by Zn2+-containing PGRPs [6].
Plants employ hydrolytic activities for the decomposition of complex bacterial structures, in which a plant enzyme activity Lysozyme1(LYS1) that hydrolyzes β (1,4) linkages between N-acetylmuramic acid and N-acetylglucosamine residues in PGN and between N-acetylglucosamine residues in chitooligosaccharides, thus PGN breakdown products produced by LYS1 are immunogenic in plants, and LYS1 mutant genotypes were immunocompromised upon bacterial infection, in which Eukaryotic hosts more generally make concerted use of PGN hydrolytic activities and of pattern recognition receptor (PRRs) to cope with bacterial infections [7]. Thus, bacterial PGN cleavage may consist of decomposition, hydrolysis, and PGN-inhibitive elongation.
In this mini-review article, bacteriolysis clearance by bacterial PGN cell wall destruction on cleavage, hydrolysis, and degradation within Cu(NO3)2 and ZnSO4 solutions, respectively are elucidated through Cu(II)- or Zn(II)-induced PGN suppressive biosynthesis, activated PGN autolysin, and PGN elongation inhibition.
Characteristics of copper nitrate (Cu(NO3)2 and zinc sulfate (ZnSO4) solutions are strong acids or strong electrolyte that, such as zinc, which is redox-inert and has only one valence state of Zn (II). In proteins, the coordination is limited by His, Cys, Glu, and sulfur donors from the side chains of a few amino acids. In zinc sulfate solution, is dissociated into aqua zinc ion [Zn (H2O)6]2+ and sulfuric ion (SO4)2―. Aqua zinc ions are liable to be bound to ligand L having a negative charge. The sulfuric ion has bactericidal activity [8].
The Halo antibacterial susceptibility test procedure had been performed, which is characteristics of finding inhibitory hal 8o zone measurements as a less qualitative antibacterial activity assay. Halo antibacterial tests have been carried out for the zinc sulfate aqueous solutions against Staphylococcus epidermidis. The other, the antibacterial reagents were prepared metallic ions 100 mM/L aqueous solutions from metallic salt reagents, wherein the crystalline powders of metallic salts of 0.01mol are dissolved in distilled water of 100 cc, preparing metallic ion concentration of 100 mM/L as antibacterial reagents (crystalline powders of 0.005 mol for zinc, copper, silver, and aluminum sulfates were used) [9].
Figure 1 shows sample appearance of halo inhibitory zone tests for Cu(NO3)2, Zn(NO3)2, AgNO3, Pb(NO3)2 nitrate solutions, in which the antibacterial active effect order is Cu2+>Zn2+>Ag+>Al3+ for the metal nitrate solutions and the highest antibacterial activity is found to be the copper nitrate solution [9].
Figure 1: Sample appearance of the halo inhibitory zone test for Cu(NO3)2, Zn(NO3)2, AgNO3, Pb(NO3)2 nitrate solutions.
Figure 2 shows sample appearance of halo inhibitory zone tests for ZnSO4, CuSO4, Ag2SO4, Al2(SO4)3 metal sulfate solutions, in which from these observations, the antibacterial active effect order is Zn2+>Cu2+>Ag+ >Al3+ for metal sulfate solutions and the highest antibacterial effect is the zinc sulfate solution, namely, Zn2+ ions in sulfate solutions have the highest antibiotics characterization [9].
Figure 2: Sample appearance of the halo inhibitory zone test for ZnSO4, CuSO4, Ag2SO4, Al2(SO4)3 Sulfate solutions.
Figure 3 shows the relationship of halo inhibitory zone (in mm) and some metallic ions of Aluminium, Zinc, Lead, Copper and Silver Nitrates and Sulfates against Staphylococcus epidermidis [9].
Figure 3: Relationship of halo inhibitory zone (in mm) and some metallic ions of Aluminium, Zinc, Lead, Copper, and Silver Nitrates and Sulfates against Staphylococcus epidermidis. The errors of Nitrates ■; Al3+ = ±4.87%, Zn2+ = ±5.57%, Pb2+ = ±8.47%, Cu2+ = ±4.39%, Ag+= ±7.96%, The errors of Sulfates □; Al3+ = ±8.29, Zn2+ = ±7.08%, Cu2+ = ±3.85%, Ag+ = ±7.11%
Table 1 shows the halo inhibitory zone (in mm) observed by halo antibacterial tests of metallic ion concentration of 100 mM/L for the nitrate and the sulfate solutions [9].
| Table 1: Halo inhibitory zone(in mm) observed by halo antibacterial tests of the metallic ion concentration of 100 mM/L for the nitrate and the sulfate solutions. | ||
| Metallic ions | Nitrates Sulfates |
Halo Inhibitory Zone (mm) |
| K+ | Nitrate Sulfate |
- - |
| Ba2+ | Nitrate Sulfate |
- - |
| Na+ | Nitrate Sulfate |
- - |
| Mg2+ | Nitrate Sulfate |
- - |
| Al3+ | Nitrate Sulfate |
3.42 3.43 |
| Zn2+ | Nitrate Sulfate |
5.89 10.2 |
| Pb2+ | Nitrate Sulfate |
5.40 - |
| Cu2+ | Nitrate Sulfate |
11.1 8.34 |
| Ag+ | Nitrate Sulfate |
5.42 4.74 |
Figure 4 shows the molecular structure of S. aureus PGN cell wall that indicates the action sites of PGN biosynthesis enzymes of TG/TP and PGN four autolysins and Lysostaphin enzyme [10]. Table 2 represents PGN biosyntheses and four autolysins against S. Aureus [10,11].
Figure 4: The molecular structure of S. aureus PGN cell wall, and the action sites of PGN biosynthesis enzymes of TG/TP and PGN, four autolysins, and Lysostaphin enzyme.
Table 2 shows PGN TG/TP biosyntheses and PGN forth autolysins against S. aureus [8,9].
| PGN biosyntheses | PGN autolysins |
・Transglycosylase, TG |
・N-acetylmuramidase |
(1) Cu(II) and Zn(II) can inhibit PGN biosyntheses TP/TG and PGN elongation
Bacteriolysis of S. aureus PGN cell wall by Cu2+ ions and Zn2+ ions is thought to be due to inhibition of PGN elongation owing to the damages of PGN, both synthetic TG/TP, and the activation of PGN major autolysin of AmiA. For the sake of the growth of S. aureus PGN cell wall, there is necessarily required for the adequate balance between PGN biosynthesis and PGN autolysin. When the balance is broken to become imbalanced, bacteriolysis and destruction of the cell wall should occur. Hence, it became apparent that PGN cleavage and hydrolysis of S. aureus PGN cell wall by Zn2+ ions are caused by inhibition of PGN elongation due to inactivation of PGN Transglycosylase (TG) or Transpeptidase (TP) and enhancement of PGN-activated autolysin amidases [4].
The other, bacteriolysis of E. coli cell wall by Cu2+ ions occurs by disruption of outer membrane structure due to degradation of lipoprotein at N-C-termini, damage of PGN synthesis TG and TP enzymes, and activation of PGN major autolysins. Furthermore, deletion of the PGN autolysin also becomes a bacteriolytic factor.
By the reaction of Cu2+ and Zn2+ ions with the S. aureus surface, Cu- and Zn-protein complexes are formed on the ground that are due to the formation of S-atom containing Cu-, Zn-cysteine complex in bacteria [12].
Cu2+ Ions induced Bacteriolysis of S. aureus PGN Cell Wall by inhibition of PGN elongation through inhibitive TG/TP enzymes and PGN-activated major autolysins [13]. Bacteriolysis by a balance deletion between synthesis enzyme and decomposition enzyme (autolysin) in the PGN cell wall: For the sake of growth of S. aureus, there is necessarily required for the adequate balance between PGN synthesis and PGN autolysin [14]. When the balance is broken by Cu2+ penetration, Cu2+ ions are self-catalytically treated as a coenzyme, that this is indicated that activation of the autolysin is preceded by bacteriolysis and killing. Copper ions inhibit PGN synthesis TG/TP against S. aureus, which damages PGN synthetic TG/TP. Cu2+ ions could activate PGN autolysin, AmiA. Hence, bacteriolysis of S. aureus PGN cell wall by Cu2+ ions is due to inhibition of PGN elongation owing to the damage of PGN synthetic TG/ TP and the activation of PGN major autolysins of AmiA [10].
Thus, copper(II) and zinc(II) ions can impair the activity of PGN biosynthesis TG and PGN elongation by bacteriolytic destruction of bacterial cell walls, causing bacterial lysis [11].
Zinc may be shown to inhibit PGN biosynthesis TG, as the bactericidal activity of Zn2+- dependent peptidoglycan recognition proteins (PGLYRPs) is salt insensitive and requires N-glycosylation of PGLYRPs, namely, zinc may be shown to inhibit PGN biosynthesis TG, but these limited PGLYRPs don’t be applicable for Gram-negative bacteria [15].
Zinc ions can inhibit PGN biosynthesis TG against S. aureus that zinc regulates PGN biosynthesis, in which Zn2+ ion can inhibit PGN synthetic enzymes that Zn2+ ions are most commonly coordinated by cysteine, followed by histidine, aspartate, and glutamate that Zn-cysteine complex in bacteria, and the Zn2+ chelation represents a potential therapeutic approach for combating biofilm growth in a wide range of bacterial biofilm-related infections [16].
Wall teichoic acids are spatial regulators of PGN cross-linking biosynthesis TP; however, it is not explicit whether zinc ions could inhibit both TG and TP enzymes of the PGN, due to the uncertain relation between wall teichoic acids biosynthesis and PGN biosynthesis [17].
Zinc can inhibit PGN biosynthesis, as zinc inhibition of phosphoglucomutase results in decreased capsule biosynthesis, and Zinc intoxication also is observed to disrupt or inhibit PGN biosynthesis [18].
Metalation of Zn2+ enzymes is activated by Zn2+ metalation via Zn2+ transporters, with Zn(II) disrupting this coordination, resulting in depression of heme synthesis but continued repression of catalase. Zn(II) intoxication leads to intracellular heme accumulation, from measurement of heme content of crude extract of cells treated with a zinc concentration of 50 μM Zn(II) [19].
Zinc ions induce bacterial cell wall functions, PGN-inhibitive synthesis enzymes of TG and TP against S. aureus, in which zinc ions inhibit PGN biosynthesis and disrupt PGN biosynthesis in the bacterial cell wall [20]. The zinc intoxication on S. pneumoniae, observing disruptions in central carbon metabolism, lipid biogenesis, and peptidoglycan biosynthesis
Thus, copper(II) and zinc(II) regulate PGN biosynthesis TG/TP, inhibit PGN synthetic enzymes, and copper and zinc intoxications can inhibit PGN biosynthesis TG against S. aureus.
(2) PGN cleavage by copper-containing autolysin and by zinc-containing autolysin amidase; AmiE, Rv3717, AmiA
Copper(II) can cleave and inhibit olymerization of glycan chains, bonding and cross-linking of ide eptide that. Cu2+ ions inhibit polymerization of glycan chains, forming a copper complex, in which there are partial action sites of glycan saccharide chains.
Copper-complexes on saccharide chains may be ・―NAG-(NAM-Cu-2O-2N-NAG)-NAM―・ that Cu2+ ions inhibit cross-linked reaction by peptide copper complex formation, bonding to side peptide chains.
Cu2+ + 2LH → CuL2 + H+
Peptide copper complex may be 3N-Cu-O, Cu (Gly-L-Ala) H2O, where Cu2+ ions react with cross-molecular penta glycine (Gly)5, copper-glycine complex may be formed.
Amino acid: Cu2+ + Gly- → Cu (Gly)+, Cu (Gly)+ + Gly― → Cu(Gly)2,
Peptido: Cu2+ + GlyGly → Cu(GlyGly), Cu(GlyGly) + Gly → Cu(GlyGlyGly) [21].
Zn PGN cleavage by zinc-containing autolysin is involved in PGN cleavage by zinc-containing autolysin amidase; AmiE, Rv3717, AmiA, where zinc(II) can cleave bacterial PGN protein. As PGN cleavage by Staphylococcal autolysin, zinc-dependent metalloenzyme AmiE is efficient as prevention of the pathogen growth [22]. The other, in the zinc ions-induced PGN inhibitive elongation due to inhibitory TG enzyme, the activated autolysin against S. aureus is involved, that inhibition of PGN elongation due to the activations of autolysins Zn2+ binding Rv3717 shows no activity on polymerized PGN, but it is induced to a potential role of N-Acetylmuramyl L-alanine Amidase [23].
Zinc(II) can cleave bacterial PGN protein, as PGN cleavage by Staphylococcal autolysin, zinc-dependent metalloenzyme AmiE, is efficient as prevention of the pathogen growth [24].
(3) PGN hydrolysis by copper-containing and zinc-containing enzymes; PGRPs, MurA, LytA, LytM = Endopeptidase, Hydrolase LytB
Cu(NO3)2-containing sol–gel surface has been performed by an antimicrobial agent to a surface coating with copper-containing enzymes, in which several tests corresponding to the utilization of the surface should be obligatory based on this assessment [1].
Bacterial PGN hydrolysis by copper enzymes that organisms exert a tight control on Cu+ transport (entry-exit) and traffic through different compartments, ensuring the homeostasis required for cuproprotein synthesis and prevention of toxic effects. Recent studies of BACTERIAL CUPROENZYMES based on biochemical, bioinformatics, and metalloproteomics approaches reveal a highly regulated system of transcriptional regulators, soluble chaperones, membrane transporters, and target cuproproteins distributed in the various bacterial compartments [25]. The other, zinc can hydrolyze bacterial PGN protein, in which PGN hydrolysis by Zn2+-containing catalytic peptidoglycan recognition proteins (PGRPs) is involved that Zn2+-dependent amidases that hydrolyze PGNs by cleaving the amide bond between MurNAc and L-alanine, in which no zinc ion is present in the PGN-binding site of human PGRP-IαC, which binds but does not hydrolyze PGNs due to substitutions in zinc-coordinating residues [26].
Amidase MurA is a PGN-hydrolase with PGN murein hydrolase activity and generalized autolysis [27], LytA amidase is the major murein hydrolase of S. pneumoniae that is considered an important virulence factor [28], and Lytic Amidase LytA is a PGN murein hydrolase with generalized autolysis [29]. LytM is a glycylglycine endopeptidase (Eps) that promotes lethal cell wall degradation after exposure to antibiotics that inhibit PG biosynthases [21]. Lysostaphin-like PGN hydrolase and glycylglycine endopeptidase LytM are efficient, in which PGN murein hydrolase activity and generalized autolysis are suitable for the enzymatically active domain of autolysin LytM [30]. PGN-hydrolases LytB is necessary for its optimal activity toward peptidoglycan hydrolysis and for pneumococcal adhesion to respiratory epithelial cells [31].
(4) PGN degradation by copper-, zinc-containing PGN inhibitive elongation [22]
Cu(II)- and Zn(II)-ions inhibit PGN elongation, and the antibacterial activity of Cu2+ and Zn2+ ions against S. aureus has been found that Cu2+ and Zn2+ ions-induced PGN autolysin activation could be enhanced the inhibition of PGN elongation simultaneously, with bacteriolysis and destruction of S. aureus PGN cell wall [32].
In vitro-described degradation or lower antimicrobial activity in the presence of Cu and antibiotics such as amoxicillin, ampicillin, meropenem, several cephalosporins, and neomycin suggest caution when using these antibiotics in patients with conditions that are linked to the elevated Cu concentration. On the other hand, the possible role of copper-dependent compounds in preventing and reversing antimicrobial resistance can be of clinical value [33].
Zinc inhibits protein substrates, such that each caspase has a variety of interactive surface elements as well as a reactive cysteine nucleophile in the active site, which could facilitate binding zinc or other biologically-relevant metals [34]. Zn2+ ions also cause tumor suppressor PTEN degradation, which is mediated by ubiquitin-associated proteolytic process in the airway epithelium, and a phosphatidylinositol 3-kinase inhibitor blocked PTEN degradation induced by Zn2+, suggesting that phosphatidylinositol 3-kinase may participate in the regulation of PTEN [35].
Thus, copper(II) and zinc(II) ions can impair the activity of PGN biosynthesis TG and PGN elongation by bacteriolytic destruction of bacterial cell walls, causing bacterial lysis [36].
However, it is thought that the activations of these PGN autolysins could simultaneously enhance the inhibitions of PGN elongation, with bacteriolysis of S. aureus PGN cell wall, namely, zinc(II) inhibits PGN biosynthesis and activates PGN autolysin, in which zinc promotes PGN cleavage, hydrolysis, activated autolysin, and inhibits elongation, and then accordingly causes PGN cleavage and leading PGN elongation inhibition. Zinc can activate PGN autolysins that are associated enzymes, which are essential for cell proliferation, and represent one promising new minimal peptidoglycan fragment. Zinc-induced PGN inhibitory synthesis corresponds to disruption of bacterial cell wall, but zinc ions may be able to inhibit PGN synthesis, TG, and PGN elongation by PGN-activated major autolysin amidase against S. aureus.
Accordingly, as mentioned above, copper(II) and zinc(II) inhibit PGN biosynthesis, activate PGN autolysin, and inhibit PGN elongation against S. aureus cell wall, in which copper-and zinc-induced PGN cleavage and hydrolysis by activated autolysins, respectively, of AmiE, Rv3717, and PGRPs, MurA, LytA, LytM-endopeptidase, and hydrolase LytB can be promoted, and then cause PGN cleavage and hydrolysis, leading to PGN elongation inhibition [36].
Bacteriolysis destruction of bacterial PGN cell wall on cleavage, hydrolysis, and degradation by Cu(NO3)2 and Zn(SO4)2 solutions, respectively, has been elucidated through Cu(II)- and Zn(II)-induced PGN suppressive biosyntheses, activated PGN autolysins, and PGN elongation inhibition.
Bacterial PGN clearance on cleavage, hydrolysis, and degradation by Cu(II) and Zn(II) ions has been investigated on the grounds of the results obtained from halo antibacterial susceptibility tests in metal nitrate and sulfate solutions against Staphylococcus Epidermidis.
In which, for the metal nitrate solutions, the antibacterial effect order is Cu2+>Zn2+>Ag+>Al3+, and the other, for the metal sulfate solutions, the antibacterial effect order is Zn2+>Cu2+>Ag+>Al3+ for copper nitrate Cu(NO3)2 and zinc sulfate (ZnSO4) solutions with a strong acid or strong electrolyte.
(1) Cu(II) and Zn(II) can inhibit PGN biosyntheses TP/TG and PGN elongation;
Copper ions inhibit PGN synthesis TG/TP against S. aureus that damages PGN synthetic TG/TP. Cu2+ ions could activate PGN autolysin, AmiA. Bacteriolysis of S. aureus PGN cell wall by Cu2+ ions is due to inhibition of PGN elongation owing to the damage of PGN synthetic TG/ TP and the activation of PGN major autolysins of AmiA. Copper(II) and zinc(II) regulate PGN biosynthesis TG/TP, inhibit PGN synthetic enzymes, and copper and zinc intoxications can inhibit PGN biosynthesis TG against S. aureus.
Zinc ions can inhibit PGN biosynthesis TG against S. aureus, as zinc regulates PGN biosynthesis, in which Zn2+ ions can inhibit PGN synthetic enzymes that Zn2+ ions are most commonly coordinated by cysteine, followed by histidine, aspartate, and glutamate that Zn-cysteine complex in bacteria, and the Zn2+ chelation represents a potential therapeutic approach for combating biofilm growth in a wide range of bacterial biofilm-related infections.
Thus, copper(II) and zinc(II) regulate PGN biosynthesis TG/TP, inhibit PGN synthetic enzymes, and copper and zinc intoxications can inhibit PGN biosynthesis TG against S. aureus.
(2) PGN cleavage by copper-containing autolysin and by zinc-containing autolysin amidase; AmiE, Rv3717, AmiA;
As PGN cleavage by Staphylococcal autolysin, copper or zinc dependent metalloenzyme AmiE is efficient as a prevention of the pathogen growth, which Cu2+ or Zn2+ binding AMIDASE Rv3717 showed no activity on polymerized PGN; however, it is induced to a potential role of N-Acetylmuramyl L-alanine Amidase
(3) PGN hydrolysis by copper-containing enzymes and by zinc-containing enzymes; PGRPs, MurA, LytA, LytM=Endopeptidase, Hydrolase LytB
Bacterial PGN hydrolysis by copper enzymes that organisms exert a tight control on Cu+ transport (entry-exit) and traffic through different compartments, ensuring the homeostasis required for cuproprotein synthesis and prevention of toxic effects. Cu(NO3)2-containing sol–gel surface has been performed by an antimicrobial agent to a surface coating with copper-containing enzymes. PGN murein hydrolase activity is involved in PGN hydrolysis by Zn2+-containing catalysis, which is consistent in PGRPs, PGN murein hydrolase activity, and generalized autolysis.
Therefore, copper nitrate and zinc sulfate solutions inhibit PGN biosynthesis and activate PGN autolysins against the S. aureus cell wall, in which the activations of these PGN autolysins could be enhanced by the inhibitions of PGN elongation simultaneously, with copper or zinc-induced PGN hydrolysis by activated autolysins of AmiE, Rv3717, and PGRPs, MurA, LytA, LytM-endopeptidase, and hydrolase LytB, with bacteriolysis of S. aureus PGN cell wall.
(4) PGN decompositions by copper- and zinc-containing PGN inhibitive elongations;
Cu ions degradation or lower antimicrobial activity in the presence of Cu and antibiotics such as amoxicillin, ampicillin, meropenem, several cephalosporins, and neomycin suggest caution when using these antibiotics in patients with conditions that are linked to the elevated Cu concentration. The possible role of copper-dependent compounds in preventing and reversing antimicrobial resistance can be of clinical value. S. aureus PGN cell wall degradation by Zn2+ ions contributes to the inhibition of PGN elongation due to the activation of PGN autolysins, amidases, and endopeptidase.
Thus, Cu2+ ions in Cu(NO3)2 solution and Zn2+ ions in ZnSO4 solution inhibit PGN biosynthesis and activate PGN autolysins against S. aureus cell wall, in which the activations of these PGN autolysins could be enhanced the inhibitions of PGN elongation simultaneously, with zinc induced PGN cleavage and hydrolysis by activated autolysins of AmiE, Rv3717 and PGRPs, MurA, LytA, LytM-endopeptidase, hydrolase LytB with bacteriolysis of S. aureus PGN cell wall that zinc promotes PGN cleavage, hydrolysis, activated autolysin, and inhibitive elongation, and then accordingly causing PGN cleavage and leading PGN elongation inhibition.
Accordingly, as mentioned above, copper(II) and zinc(II) inhibit PGN biosynthesis, activate PGN autolysin, and inhibit PGN elongation against S. aureus cell wall, in which copper-and zinc-induced PGN cleavage, hydrolysis, and degradation by activated autolysins, respectively, of AmiE, Rv3717, and PGRPs, MurA, LytA, LytM-endopeptidase, and hydrolase LytB can be promoted, and then cause PGN cleavage, hydrolysis, and degradation, leading to PGN elongation inhibition.
Acknowledgement
The author thanks Chemistry Teacher MC. Reiko Kobayashi et al; Research Group in Kumagaya Woman’s High School (Kumagaya-Shi, Saitama-Ken) for anti-bacterial metal-sulfates and metal-nitrates halo-test experiments.
- Toplitsch D, Lackner JM, Schwan AM, Hinterer A, Stögmüller P, Horn K, et al. Antimicrobial activity of a novel Cu(NO3)2-containing sol–gel surface under different testing conditions. Materials. 2021;14:6488:1-14. Available from: https://doi.org/10.3390/ma14216488
- Abdalkader FA. Antibacterial effect of different concentrations of zinc sulfate on multidrug resistant pathogenic bacteria. Sys Rev Pharm. 2020;11(3):282-288. Available from: http://dx.doi.org/10.5530/srp.2019.2.04
- Murphey ED, Sherwood ER. Pretreatment with the gram-positive bacterial cell wall molecule peptidoglycan improves bacterial clearance and decreases inflammation and mortality in mice challenged with Pseudomonas aeruginosa. Microbes Infect. 2008;10(12-13):1244-1250. Available from: https://doi.org/10.1016/j.micinf.2008.07.021
- Ishida T. Insights into metallic Ag+, Cu2+, Zn2+ ions-induced bacteriolytic mechanism against S. aureus and E. coli. Catal Res. 2023;3(1):1-12. Available from: https://www.jcatalysis.com/articles/insights-into-metallic-ag-cu2-zn2-ions-induced-bacteriolytic-mechanism-against-s-aureus-and-e-coli.pdf
- Büttner FM, Zoll S, Nega M, Götz F, Stehle T. Structure-function analysis of Staphylococcus aureus amidase reveals the determinants of peptidoglycan recognition and cleavage. J Biol Chem. 2014;289(16):11083-11094. Available from: https://doi.org/10.1074/jbc.m114.557306
- Guan R, Roychowdhury A, Ember B, Kumar S, Boons GJ, Mariuzza RA. Structural basis for peptidoglycan binding by peptidoglycan recognition proteins. Proc Natl Acad Sci U S A. 2004;101(49):17168-17173. Available from: https://doi.org/10.1073/pnas.0407856101
- Liu X, Grabherr HM, Willmann R, Kolb D, Brunner F, Bertsche U, Kühner D, Franz-Wachtel M, Amin B, Felix G, Ongena M, Nürnberger T, Gust AA. Host-induced bacterial cell wall decomposition mediates pattern-triggered immunity in Arabidopsis. Elife. 2014;3:1-24. Available from: https://doi.org/10.7554/elife.01990
- Ishida T. Bacteriolyses of bacterial cell walls by Cu(II) and Zn(II) ions based on antibacterial results of dilution medium method and halo antibacterial test. J Adv Res Biotechnol. 2017;2(2):1-12. Available from: https://symbiosisonlinepublishing.com/biotechnology/biotechnology20.pdf
- Ishida T, Kobayashi R, Inose W. Anti-bacterial activity on halo antibacterial susceptibility test by metal sulfates and nitrides solutions. J Japan Res Inst Adv Copper-Base Mater Technol. 2017;56(1):329-333.
- Crichton RT, Shioya M. Biological inorganic chemistry. Tokyo: Tokyo Kagaku-Dojin Limited; 2016;175-188. Available from: https://miguelprudencio.com/wp-content/uploads/Crichton-Biological-Inorganic-Chemistry-An-Introduction.pdf
- Zoll S, Patzold B, Schlag M, Gotz F, Kalbacher H, Stehle T. Structural basis of cell wall cleavage by a staphylococcal autolysin. PLoS Pathog. 2010;6(3):e1000807. Available from: https://doi.org/10.1371/journal.ppat.1000807
- Humann J, Lenz LL. Bacterial peptidoglycan-degrading enzymes and their impact on host muropeptidase detection. J Innate Immun. 2009;1(2):88-97. Available from: https://doi.org/10.1159/000181181
- Ishida T. Anti-bacterial mechanism for metallic Ag+, Cu2+, Zn2+ ions-induced bacteriolysis on disruptive OM Lpp and PGN inhibitive elongations against S. aureus and E. coli. Mathews J Cytol Histol. 2022;6(1):1-13. Available from: https://www.mathewsopenaccess.com/scholarly-articles/anti-bacterial-mechanism-for-metallic-ag-cu2-zn2-ions-induced-bactertiolysis-on-disruptive-om-lpp-and-pgn-inhibitive-elongations-against-s-aureus-and-e-coli.pdf
- Ishida T. Antibacterial mechanism of bacteriolyses of bacterial cell walls by zinc(II) ion induced activations of PGN autolysins, and DNA damages. J Genes Proteins. 2017;1(1):1-7. Available from: https://www.scitechnol.com/peer-review-pdfs/antibacterial-mechanism-of-bacteriolyses-of-bacterial-cell-walls-by-zinc-ion-induced-activations-of-pgn-autolysins-and-dna-damages-juTB.pdf
- Wang M, Liu LH, Wang S, Li X, Lu X, Gupta D, et al. Human peptidoglycan recognition proteins require zinc to kill both gram-positive and gram-negative bacteria and are synergistic with antibacterial peptides. J Immunol. 2007;178:3116-3125. Available from: https://doi.org/10.4049/jimmunol.178.5.3116
- Conrady DG, Brescia CC, Horii K, Weiss AA, Hassett DJ, Herr AB. A zinc-dependent adhesion module is responsible for intercellular adhesion in staphylococcal biofilms. Proc Natl Acad Sci U S A. 2008;105(49):19456-19461. Available from: https://doi.org/10.1073/pnas.0807717105
- Atilano ML, Pereira PM, Yates J, Reed P, Veiga H, Pinho MG, et al. Teichoic acids are temporal and spatial regulators of peptidoglycan cross-linking in Staphylococcus aureus. Proc Natl Acad Sci U S A. 2010;107(44):18991-18996. Available from: https://doi.org/10.1073/pnas.1004304107
- Ong CY, Walker MJ, McEwan AG. Zinc disrupts central carbon metabolism and capsule biosynthesis in Streptococcus pyogenes. Sci Rep. 2015;5:10799. Available from: https://www.nature.com/articles/srep10799
- Chandrangsu P, Helmann JD. Intracellular Zn(II) intoxication leads to dysregulation of the PerR regulon resulting in heme toxicity in Bacillus subtilis. PLoS Genet. 2016;12(12):e1006515. Available from: https://doi.org/10.1371/journal.pgen.1006515
- Brazel EB, Tan A, Neville SL, Iverson AR, Udagedara SR, Cunningham BA, et al. Dysregulation of Streptococcus pneumoniae zinc homeostasis breaks ampicillin resistance in a pneumonia infection model. Cell Rep. 2022;38(2):110202. Available from: https://doi.org/10.1016/j.celrep.2021.110202
- Ishida T. Mechanism of antibacterial activities of Cu(II) ions against Staphylococcus aureus and Escherichia coli on the ground of results obtained from dilution medium method. Virol Immunol J. 2017;1(3):1-8. Available from: https://medwinpublishers.com/VIJ/VIJ16000117.pdf
- Mahmood WS. Controlling of bacterial elongation growth by studying the factors affecting it. World J Mod Res Methodol. 2023;2(11):2835-3072. Available from: https://doi.org/10.15226/2475-4714/2/2/00120
- Prigozhin DM, Mavrici D, Huizar JP, Vansell HJ, Alber T. Structural and biochemical analyses of Mycobacterium tuberculosis N-acetylmuramyl-L-alanine amidase Rv3717 point to a role in peptidoglycan fragment recycling. J Biol Chem. 2013;288(44):31549-31555. Available from: https://doi.org/10.1074/jbc.M113.510792
- Zoll S, Pätzold B, Schlag M, Götz F, Kalbacher H, Stehle T. Structural basis of cell wall cleavage by a staphylococcal autolysin. PLoS Pathog. 2010;6:1-13. Available from: https://journals.plos.org/plospathogens/article?id=10.1371/journal.ppat.1000807
- Argüello JM, Raimunda D, Padilla-Benavides T. Mechanisms of copper homeostasis in bacteria. Front Cell Infect Microbiol. 2013;3:73. Available from: https://doi.org/10.3389/fcimb.2013.00073
- Guan R, Roychowdury A, Ember B, Kumar S, Boons GJ, Mariuzza RA. Crystal structure of a peptidoglycan recognition protein in complex with a muramyl tripeptide from gram-positive bacteria. J Endotoxin Res. 2005;11(1):1-6. Available from: https://doi.org/10.1179/096805105225006713
- Carroll SA, Hain T, Technow U, Darji A, Pashalidis P, Joseph SW, et al. Identification and characterization of a peptidoglycan hydrolase, MurA of Listeria monocytogenes, a muramidase needed for cell separation. J Bacteriol. 2003;185(23):6801-6808. Available from: https://doi.org/10.1128/jb.185.23.6801-6808.2003
- Paton JC, Andrew PW, Boulnois GJ, Mitchell TJ. Molecular analysis of the pathogenicity of Streptococcus pneumoniae: the role of pneumococcal proteins. Annu Rev Microbiol. 1993;47:89-115. Available from: https://doi.org/10.1146/annurev.mi.47.100193.000513
- Mellroth P, Sandalova T, Kikhney A, Vilaplana F, Hesek D, Lee M, et al. Structural and functional insights into peptidoglycan access for the lytic amidase LytA of Streptococcus pneumoniae. mBio. 2014;5(1):1-10. Available from: https://doi.org/10.1128/mbio.01120-13
- Jagielska E, Chojnacka O, Sabata I. LytM fusion with SH3b-like domain expands its activity to physiological conditions. Microb Drug Resist. 2016;22(6):461-469. Available from: https://doi.org/10.1089/mdr.2016.0053
- Bai XH, Chen HJ, Jiang YL, Wen Z, Huang Y, Cheng W, Li Q, Qi L, Zhang JR, Chen Y, Zhou CZ. Structure of pneumococcal peptidoglycan hydrolase LytB reveals insights into bacterial cell wall remodeling and pathogenesis. J Biol Chem. 2014;289:1-10. Available from: https://doi.org/10.1074/jbc.m114.579714
- Godoy-Gallardo M, Hoyos-Nogué M, Eckhard U, Gil FJ, Delgado LM, Perez RA, de Roo Puente YJD. Antibacterial approaches in tissue engineering using metal ions and nanoparticle. Bioact Mater. 2021. Available from: https://doi.org/10.1016/j.bioactmat.2021.04.033
- Božić Cvijan B, Korac Jaći J, Bajceti M. The impact of copper ions on the activity of antibiotic drugs. Molecules. 2023;28:5133:1-15. Available from: https://doi.org/10.3390/molecules28135133
- Wu W, Wang X, Zhang W, Reed W, Samet JM, Whang YE, Ghio AJ. Zinc-induced PTEN protein degradation through the proteasome pathway in human airway epithelial cells. J Biol Chem. 2003;278(30):28258-28263. Available from: https://doi.org/10.1074/jbc.m303318200
- Ishida T. Antibacterial mechanism of bacteriolyses of bacterial cell walls by zinc(II) ion induced activations of PGN autolysins, and DNA damages. J Genes Proteins. 2017;1(1):1-7. Available from: https://www.scitechnol.com/peer-review-pdfs/antibacterial-mechanism-of-bacteriolyses-of-bacterial-cell-walls-by-zinc-ion-induced-activations-of-pgn-autolysins-and-dna-damages-juTB.pdf
- Eron SJ, MacPherson DJ, Dagbay KB, Hardy JA. Multiple mechanisms of zinc-mediated inhibition for the apoptotic caspases -3, -6, -7, and -8. ACS Chem Biol. 2018;13(5):1279-1290. Available from: https://doi.org/10.1021/acschembio.8b00064